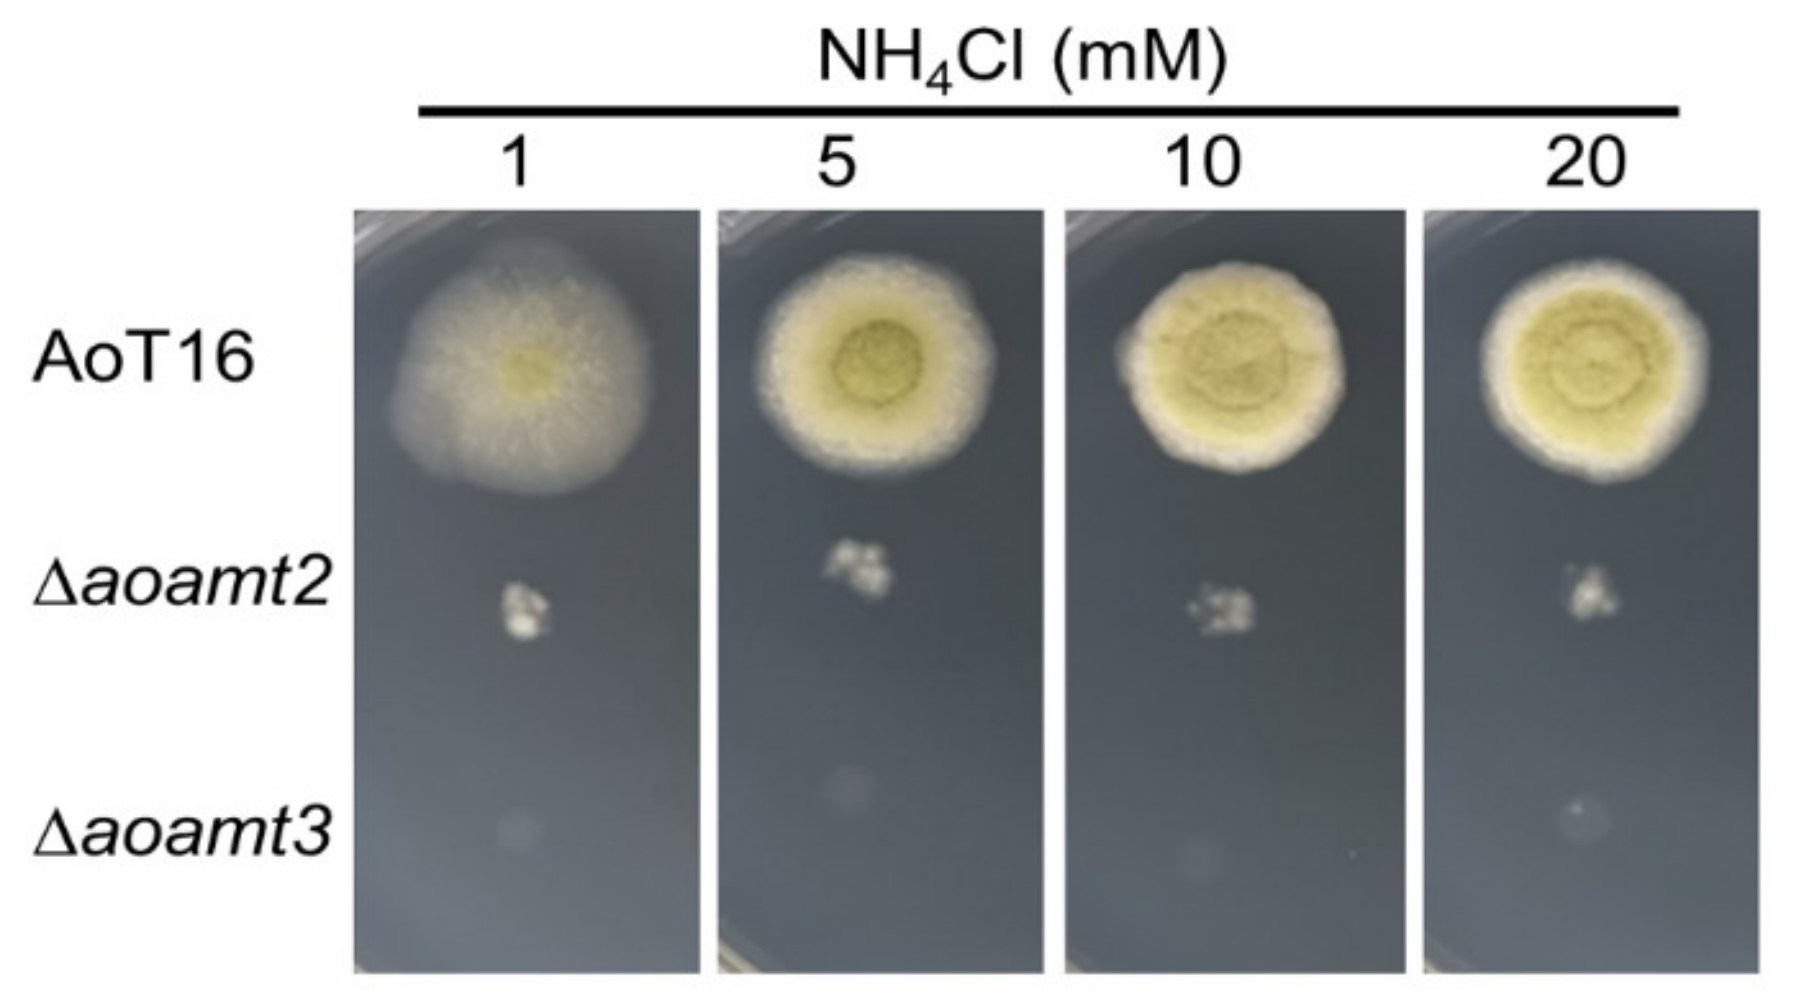
Ijms 23 07567 g005

The Exploring Functional Role of Ammonium Transporters of Aspergillus oryzae in Nitrogen Metabolism: Challenges towards Cell Biomass Production
Abstract
1. Introduction
2. Results and Discussion
2.1. Identification and Characterization of the Ammonium Transporter Sequences of A. oryzae
2.2. Differential Expression of Ammonium Transporter Genes (Aoamts) in A. oryzae by Ammonium Treatment
2.3. Assessing the Role of Ammonium Transporters in Phenotypic Growth on Solid Medium and Nitrogen Metabolism of A. oryzae
2.4. Effect of Aoamt3 Overexpression of on Cell Biomass Production of A. oryzae
3. Methods and Materials
3.1. Microbial Strains and Cultivation
3.2. Identification of Aoamt Homologs of A. oryzae
3.3. Transmembrane Topology Prediction
3.4. Analysis of Phylogenetic Tree and Conserved Motifs of the Aoamt Proteins
3.5. Plasmid Construction, Fungal Transformation, and Verification of Transformants
3.6. Submerged Cultivation for Gene Expression Analysis and Determination of Ammonium Consumption
3.7. RT-qPCR Analysis
3.8. Radial Growth and Cell Biomass Measurements
3.9. Determination of Residual Glucose and Ammonium Concentrations
3.10. Statistical Analyses
4. Conclusions
Supplementary Materials
Author Contributions
Funding
Institutional Review Board Statement
Informed Consent Statement
Data Availability Statement
Acknowledgments
Conflicts of Interest
References
- Tudzynski, B. Nitrogen regulation of fungal secondary metabolism in fungi. Front. Microbiol. 2014, 5, 656. [Google Scholar] [CrossRef] [PubMed]
- Meti, R.S.; Ambarish, S.; Khajure, P.V. Enzymes of ammonia assimilation in fungi: An overview. Recent Res. Sci. Technol. 2011, 2, 28–38. [Google Scholar]
- Pfannmüller, A.; Boysen, J.M.; Tudzynski, B. Nitrate assimilation in Fusarium fujikuroi is controlled by multiple levels of regulation. Front. Microbiol. 2017, 8, 381. [Google Scholar] [CrossRef] [PubMed]
- Macios, M.; Caddick, M.X.; Weglenski, P.; Scazzocchio, C.; Dzikowska, A. The GATA factors AREA and AREB together with the co-repressor NMRA, negatively regulate arginine catabolism in Aspergillus nidulans in response to nitrogen and carbon source. Fungal Genet. Biol. 2012, 49, 189–198. [Google Scholar] [CrossRef] [PubMed]
- Marzluf, G.A. Genetic regulation of nitrogen metabolism in the fungi. Microbiol. Mol. Biol. Rev. 1997, 61, 17–32. [Google Scholar]
- Michielse, C.B.; Pfannmüller, A.; Macios, M.; Rengers, P.; Dzikowska, A.; Tudzynski, B. The interplay between the GATA transcription factors AreA, the global nitrogen regulator and AreB in Fusarium fujikuroi. Mol. Biol. 2014, 91, 472–493. [Google Scholar]
- Wiame, J.M.; Grenson, M.; Arst, H.N. Nitrogen catabolite repression in yeasts and filamentous fungi. Adv. Microb. Physiol. 1985, 26, 1–88. [Google Scholar]
- Jiang, J.; Zhao, J.; Duan, W.; Tian, S.; Wang, X.; Zhuang, H.; Fu, J.; Kang, Z. TaAMT2;3a, a wheat AMT2-type ammonium transporter, facilitates the infection of stripe rust fungus on wheat. BMC Plant Biol. 2019, 19, 239. [Google Scholar] [CrossRef]
- ter Schure, E.G.; van Riel, N.A.; Verrips, C.T. The role of ammonia metabolism in nitrogen catabolite repression in Saccharomyces cerevisiae. FEMS Microbiol. Rev. 2000, 24, 67–83. [Google Scholar] [CrossRef]
- Johansen, A.; Finlay, R.D.; Olsson, P.A. Nitrogen metabolism of external hyphae of the arbuscular mycorrhizal fungus Glomus intraradices. New Phytol. 1996, 133, 705–712. [Google Scholar] [CrossRef]
- Krappmann, S.; Braus, G.H. Nitrogen metabolism of Aspergillus and its role in pathogenicity. Med. Mycol. 2005, 43, S31–S40. [Google Scholar] [CrossRef] [PubMed]
- Javelle, A.; Morel, A.; Rodríguez-Pastrana, B.-A.; Botton, B.; André, B.; Marini, A.M.; Brun, A.; Chalot, M. Molecular characterization, function and regulation of ammonium transporters (Amt) and ammoniummetabolizing enzymes (GS, NADP-GDH) in the ectomycorrhizal fungus Hebeloma cylindrosporum. Mol. Microbiol. 2003, 47, 411–430. [Google Scholar] [CrossRef] [PubMed]
- Marini, A.M.; Vissers, S.; Urrestarazu, A.; André, B. Cloning and expression of the MEP1 gene encoding an ammonium transporter in Saccharomyces cerevisiae. EMBO J. 1994, 13, 3456–3463. [Google Scholar] [CrossRef] [PubMed]
- Ninnemann, O.; Jauniaux, J.C.; Frommer, W.B. Identification of a high affinity ammonium transporter from plants. EMBO J. 1994, 13, 3464–3471. [Google Scholar] [CrossRef]
- Monahan, B.J.; Fraser, J.A.; Hynes, M.J.; Davis, M.A. Isolation and characterization of two ammonium permease genes, meaA and mepA, from Aspergillus nidulans. Eukaryot. Cell 2002, 1, 85–94. [Google Scholar] [CrossRef][Green Version]
- Monahan, B.J.; Unkles, S.E.; Tsing, I.T.; Kinghorn, J.R.; Hynes, M.J.; Davis, M.A. Mutation and functional analysis of the Aspergillus nidulans ammonium permease MeaA and evidence for interaction with itself and MepA. Fungal Genet. Biol. 2002, 36, 35–46. [Google Scholar] [CrossRef]
- Moonjely, S.; Zhang, X.; Fang, W.; Bidochka, M.J. Metarhizium robertsii ammonium permeases (MepC and Mep2) contribute to rhizoplane colonization and modulates the transfer of insect derived nitrogen to plants. PLoS ONE 2019, 14, e0223718. [Google Scholar] [CrossRef]
- Teichert, S.; Rutherford, J.C.; Wottawa, M.; Heitman, J.; Tudzynski, B. Impact of ammonium permeases MepA, MepB, and MepC on nitrogen-regulated secondary metabolism in Fusarium fujikuroi. Eukaryot. Cell 2008, 7, 187–201. [Google Scholar] [CrossRef]
- Monahan, B.J.; Askin, M.C.; Hynes, M.J.; Davis, M.A. Differential expression of Aspergillus nidulans ammonium permease genes is regulated by GATA transcription factor AreA. Eukaryot. Cell 2006, 5, 226–237. [Google Scholar] [CrossRef]
- Daba, G.M.; Mostafa, F.A.; Elkhateeb, W.A. The ancient koji mold (Aspergillus oryzae) as a modern biotechnological tool. Bioresour. Bioprocess. 2021, 8, 52. [Google Scholar] [CrossRef]
- de Vries, R.P.; Riley, R.; Wiebenga, A.; Aguilar-Osorio, G.; Amillis, S.; Uchima, C.A.; Anderluh, G.; Asadollahi, M.; Askin, M.; Barry, K.; et al. Comparative genomics reveals high biological diversity and specific adaptationsin the industrially and medically important fungal genus Aspergillus. Genome Biol. 2017, 18, 28. [Google Scholar] [CrossRef] [PubMed]
- He, B.; Tu, Y.; Jiang, C.; Zhang, Z.; Li, Y.; Zeng, B. Functional genomics of Aspergillus oryzae: Strategies and progress. Microorganisms 2019, 7, 103. [Google Scholar] [CrossRef] [PubMed]
- Thammarongtham, C.; Nookaew, I.; Vorapreeda, T.; Srisuk, T.; Land, M.L.; Jeennor, S.; Laoteng, K. Genome characterization of oleaginous Aspergillus oryzae BCC 7051: A potential fungal-based platform for lipid production. Curr. Microbiol. 2018, 75, 57–70. [Google Scholar] [CrossRef]
- Krogh, A.; Larsson, B.; von Heijne, G.; Sonnhammer, E.L. Predicting transmembrane protein topology with a hidden Markov model: Application to complete genomes. J. Mol. Biol. 2001, 305, 567–580. [Google Scholar] [CrossRef] [PubMed]
- Ellerbeck, M.; Schüßler, A.; Brucker, D.; Dafinger, C.; Loos, F.; Brachmann, A. Characterization of three ammonium transporters of the Glomeromycotan fungus Geosiphon pyriformis. Eukaryot. Cell 2013, 12, 1554–1562. [Google Scholar] [CrossRef] [PubMed]
- Neuhäuser, B. Distinct transport mechanism in Candida albicans methylammonium permeases. Mycol. Prog. 2020, 19, 1143–1149. [Google Scholar] [CrossRef]
- Paul, J.A.; Barati, M.T.; Cooper, M.; Perlin, M.H. Physical and genetic interaction between ammonium transports and the signaling protein Rho1 in the plant pathogen Ustilago maydis. Eukaryot. Cell 2014, 12, 1328–1336. [Google Scholar] [CrossRef][Green Version]
- Marini, A.M.; Soussi-Boudekou, S.; Vissers, A.; Andre, B. A family of ammonium transporters in Saccharomyces cerevisiae. Mol. Cell. Biol. 1997, 17, 4282–4293. [Google Scholar] [CrossRef] [PubMed]
- Biswas, K.; Morschhäuser, J. The Mep2p ammonium permease controls nitrogen starvation-induced filamentous growth in Candida albicans. Mol. Microbiol. 2005, 56, 649–669. [Google Scholar] [CrossRef]
- Andrade, S.L.A.; Dickmanns, A.; Ficner, R.; Einsle, O. Crystal structure of the archaeal ammonium transporter Amt-1 from Archaeoglobus fulgidus. Proc. Natl. Acad. Sci. USA 2005, 102, 14994–14999. [Google Scholar] [CrossRef]
- Loque, D.; Lalonde, S.; Looger, L.L.; von Wiren, N.; Frommer, W.B. A cytosolic trans-activation domain essential for ammonium uptake. Nature 2007, 446, 195–198. [Google Scholar] [CrossRef] [PubMed]
- Pantoja, O. High affinity ammonium transporters: Molecular mechanism of action. Front. Plant Sci. 2012, 3, 34. [Google Scholar] [CrossRef] [PubMed]
- Mikros, E.; Diallinas, G. Tales of tails in transporters. Open Biol. 2019, 9, 190083. [Google Scholar] [CrossRef] [PubMed]
- van den Berg, B.; Lister, S.; Rutherford, J.C. Ammonium transceptors: Novel regulators of fungal development. PLoS Pathog. 2019, 15, e1008059. [Google Scholar] [CrossRef] [PubMed]
- Ganz, P.; Ijato, T.; Porras-Murrilo, R.; Stührwohldt, N.; Ludewig, U.; Neuhäuser, B. A twin histidine motif is the core structure for high-affinity substrate selection in plant ammonium transporters. J. Biol. Chem. 2020, 295, 3362–3370. [Google Scholar] [CrossRef]
- Javelle, A.; Lupo, D.; Zheng, L.; Li, X.D.; Winkler, F.K.; Merrick, M. An usual twin-his arrangement in the pore of ammonia channels is essential for substrate conductance. J. Biol. Chem. 2006, 281, 39492–39498. [Google Scholar] [CrossRef]
- Wang, J.; Fulford, T.; Shao, Q.; Javelle, A.; Yang, H.; Zhu, W.; Merrick, M. Ammonium transport proteins with changes in one of the conserved pore histidines have different performance in ammonia and methylamine conduction. PLoS ONE 2013, 8, e62745. [Google Scholar] [CrossRef]
- Williamson, G.; Brito, A.S.; Bizior, A.; Tamburrino, G.; Mirendela, G.D.; Harris, T.; Hoskisson, P.A.; Zachariae, U.; Marini, A.M.; Boeckstaens, M.; et al. Coexistence of ammonium transporter and channel mechanisms in Amt-Mep-Rh twin-his variants impairs the filamentation signaling capacity of fungal Mep2 transceptors. mBio 2022, 13, e02913-21. [Google Scholar] [CrossRef]
- Russ, W.P.; Engelman, D.M. The GxxxG motif: A framework for transmembrane helix-helix association. J. Mol. Biol. 2000, 296, 911–919. [Google Scholar] [CrossRef]
- Teese, M.G.; Langosch, D. Role of GxxxG motifs in transmembrane domain interactions. Biochemistry 2015, 54, 5125–5135. [Google Scholar] [CrossRef]
- Crooks, G.E.; Hon, G.; Chandonia, J.M.; Brenner, S.E. WebLogo: A sequence logo generator. Genome Res. 2004, 14, 1188–11909. [Google Scholar] [CrossRef] [PubMed]
- Mitsuzawa, H. Ammonium transporter genes in the fission yeast Schizosaccharomyces pombe: Role in ammonium uptake and a morphological transition. Genes Cell. 2006, 11, 1183–1195. [Google Scholar] [CrossRef] [PubMed]
- Nierman, W.C.; Yu, J.; Fedorova-Abrams, N.D.; Losada, L.; Cleveland, T.E.; Bhatnagar, D.; Bennett, J.W.; Dean, R.; Payne, G.A. Genome Sequence of Aspergillus flavus NRRL 3357, a strain that causes aflatoxin contamination of food and feed. Genome Announc. 2015, 3, e00168-15. [Google Scholar] [CrossRef] [PubMed]
- Larkin, M.A.; Blackshields, G.; Brown, N.P.; Chenna, R.; McGettigan, P.A.; McWilliam, H.; Valentin, F.; Wallace, I.M.; Wilm, A.; Lopez, R.; et al. Clustal W and Clustal X version 2.0. Bioinformatics 2007, 23, 2947–2948. [Google Scholar] [CrossRef]
- Tamura, K.; Stecher, G.; Kumar, S. MEGA11: Molecular evolutionary genetics analysis version 11. Mol. Biol. Evol. 2021, 38, 3022–3027. [Google Scholar] [CrossRef] [PubMed]
- Le, S.Q.; Gascuel, O. An improved general amino acid replacement matrix. Mol. Biol. Evol. 2008, 25, 1307–1320. [Google Scholar] [CrossRef] [PubMed]
- Russo, C.A.M.; Selvatti, A.P. Bootstrap and rogue identification tests for phylogenetic analyses. Mol. Biol. Evol. 2018, 35, 2327–2333. [Google Scholar] [CrossRef]
- Mistry, J.; Chuguransky, S.; Williams, L.; Qureshi, M.; Salazar, G.A.; Sonnhammer, E.L.L.; Tosatto, S.C.; Paladin, L.; Raj, S.; Richardson, L.J.; et al. Pfam: The protein families database in 2021. Nucleic Acids Res. 2021, 49, D412–D419. [Google Scholar] [CrossRef]
- Sievers, F.; Higgins, D.G. Clustal Omega for making accurate alignments of many protein sequences. Protein Sci. 2018, 27, 135–145. [Google Scholar] [CrossRef]
- Pahirulzaman, K.A.; Williams, K.; Lazarus, C.M. A toolkit for heterologous expression of metabolic pathways in Aspergillus oryzae. Meth. Enzymol. 2012, 517, 241–260. [Google Scholar]
- Lorang, J.M.; Tuori, R.P.; Martinez, J.P.; Sawyer, T.L.; Redman, R.S.; Rollins, J.A.; Wolpert, T.J.; Johnson, K.B.; Rodriguez, R.J.; Dickman, M.B.; et al. Green fluorescent protein is lighting up fungal biology. Appl. Environ. Microbiol. 2001, 67, 1987–1994. [Google Scholar] [CrossRef] [PubMed]
- Chutrakul, C.; Jeennor, S.; Panchanawaporn, S.; Cheawchanlertfa, P.; Suttiwattanakul, S.; Veerana, M.; Laoteng, K. Metabolic engineering of long chain-polyunsaturated fatty acidbiosynthetic pathway in oleaginous fungus for dihomo-gammalinolenic acid production. J. Biotechnol. 2016, 218, 85–93. [Google Scholar] [CrossRef] [PubMed]
- Jeennor, S.; Anantayanon, J.; Panchanawaporn, S.; Khoomrung, S.; Chutrakul, C.; Laoteng, K. Reengineering lipid biosynthetic pathway of Aspergillus oryzae for enhanced production of gamma-linolenic acid and dihomo-gamma-linolenic acid. Gene 2019, 706, 106–114. [Google Scholar] [CrossRef] [PubMed]
- Livak, K.J.; Schmittgen, T.D. Analysis of relative gene expression data using real-time quantitative PCR and the 2−ΔΔCT method. Methods 2001, 25, 402–408. [Google Scholar] [CrossRef]
- Laoteng, K.; Jitsue, S.; Dandusitapunth, Y.; Cheevadhanarak, S. Ethanol-induced changes in expression profiles of cell growth, fatty acid and desaturase genes of Mucor rouxii. Fungal Genet. Biol. 2008, 45, 61–67. [Google Scholar] [CrossRef]
- Weatherburn, M.W. Phenol-hypochlorite reaction for determination of ammonia. Anal. Chem. 1967, 39, 971–974. [Google Scholar] [CrossRef]

| Growth Parameter | oeaoamt3 | AoT16 |
|---|---|---|
| Biomass (g/L) | 16.91 ± 0.34 | 17.60 ± 0.13 |
| Productivity (g/L/h) | 0.35 ± 0.01 | 0.37 ± 0.00 |
| Glucose consumption (g/L) | 30.85 ± 1.08 * | 41.46 ± 0.18 |
| Glucose consumption rate (g/h) | 0.65 ± 0.01 * | 0.86 ± 0.00 |
| Biomass yield (g cell/g substrate) | 0.55 ± 0.01 * | 0.42 ± 0.00 |
Publisher’s Note: MDPI stays neutral with regard to jurisdictional claims in published maps and institutional affiliations. |
© 2022 by the authors. Licensee MDPI, Basel, Switzerland. This article is an open access article distributed under the terms and conditions of the Creative Commons Attribution (CC BY) license (https://creativecommons.org/licenses/by/4.0/).
Share and Cite
Chutrakul, C.; Panchanawaporn, S.; Vorapreeda, T.; Jeennor, S.; Anantayanon, J.; Laoteng, K. The Exploring Functional Role of Ammonium Transporters of Aspergillus oryzae in Nitrogen Metabolism: Challenges towards Cell Biomass Production. Int. J. Mol. Sci. 2022, 23, 7567. https://doi.org/10.3390/ijms23147567
Chutrakul C, Panchanawaporn S, Vorapreeda T, Jeennor S, Anantayanon J, Laoteng K. The Exploring Functional Role of Ammonium Transporters of Aspergillus oryzae in Nitrogen Metabolism: Challenges towards Cell Biomass Production. International Journal of Molecular Sciences. 2022; 23(14):7567. https://doi.org/10.3390/ijms23147567
Chicago/Turabian StyleChutrakul, Chanikul, Sarocha Panchanawaporn, Tayvich Vorapreeda, Sukanya Jeennor, Jutamas Anantayanon, and Kobkul Laoteng. 2022. "The Exploring Functional Role of Ammonium Transporters of Aspergillus oryzae in Nitrogen Metabolism: Challenges towards Cell Biomass Production" International Journal of Molecular Sciences 23, no. 14: 7567. https://doi.org/10.3390/ijms23147567
APA StyleChutrakul, C., Panchanawaporn, S., Vorapreeda, T., Jeennor, S., Anantayanon, J., & Laoteng, K. (2022). The Exploring Functional Role of Ammonium Transporters of Aspergillus oryzae in Nitrogen Metabolism: Challenges towards Cell Biomass Production. International Journal of Molecular Sciences, 23(14), 7567. https://doi.org/10.3390/ijms23147567

